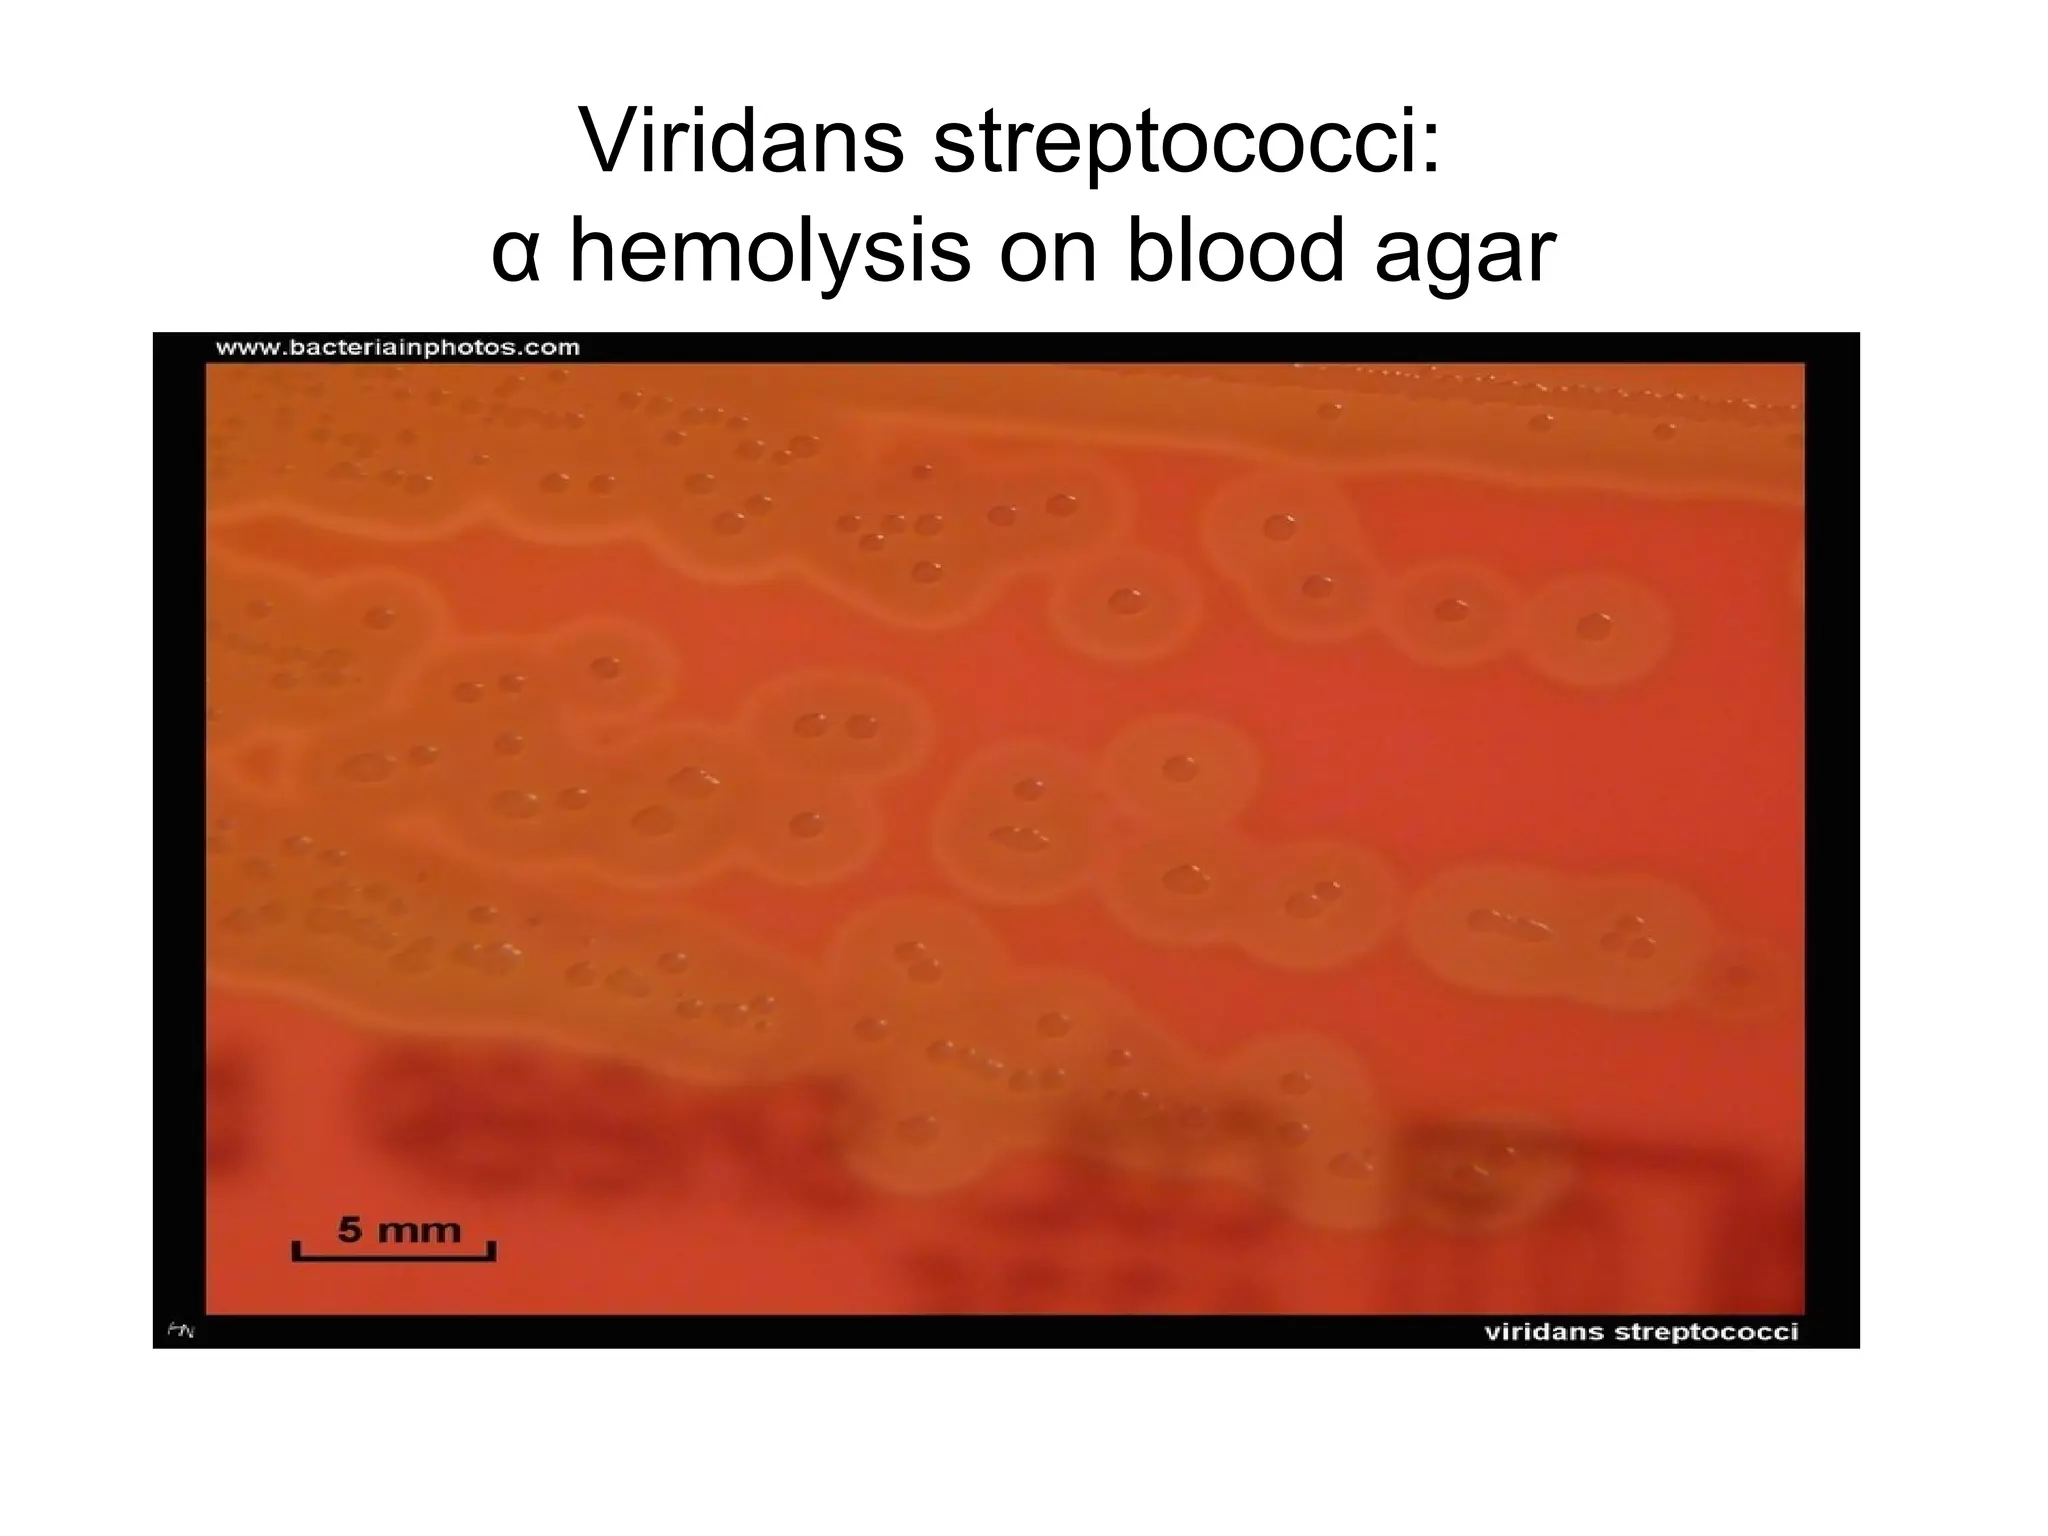

1st Year Medical School Classes 1st is the correct numeric abbreviation of first 1th is a grammatical error and you should never use it Remembering how to correctly write ordinals can be challenging
This page shows how we make and say the ordinal numbers like 1st 2nd 3rd in English Vocabulary for ESL learners and teachers An Ordinal Number is a number that tells the position of something in a list such as 1st 2nd 3rd 4th 5th etc Most ordinal numbers end in th except when the final word is one first 1st
1st Year Medical School Classes
1st Year Medical School Classes
https://i.pinimg.com/736x/5f/b7/0e/5fb70e727f2ce147f0be749c62b2f779.jpg
PLME Students Discuss Balancing Pre med Education With Outside
https://snworksceo.imgix.net/bdh/ba6a9d39-306e-4e48-8a2f-3a25e76c460d.sized-1000x1000.jpeg?w=1000
Annual Plan Template Templates At Allbusinesstemplates
https://www.allbusinesstemplates.com/thumbs/d72cc940-93e5-480b-9fa5-7723168581f1_1.png
We have included all of the ordinal numbers from 1st to 31st because they are needed when you give a date in English The ordinal numbers from 1st to 31st in English are 1st first They are numbers such as 1st first 2nd second 3rd third 4th fourth and so on A cardinal number on the other hand refers to numbers that indicate how many of
First 1st second 2nd third 3rd fourth 4th twenty sixth 26th hundred and first 101st Titles In names for kings and queens ordinal numbers are written in Roman numbers In When writing ordinal numbers such as 1st 2nd 3rd etc you should use the last two letters on the word as it would be if you wrote out the whole word Below are the ordinal numbers both
More picture related to 1st Year Medical School Classes
45 Medical School Statistics Every Student Should Know Etactics
https://images.squarespace-cdn.com/content/v1/5aa96c579772aea9adaa2ef7/1610029122291-MYSHZ5PNY7Q4IWSQSXH9/MedicalSchoolStatistics_AcceptanceRates_0121.png
Internal Medicine Books For Medical Students CollegeLearners
https://www.mbbsinbangladesh.in/wp-content/uploads/2021/01/First-Year-MBBS-Bangladesh-Books-List.jpg
FIRST YEAR MED SCHOOL SUBJECTS Sample Lectures And Exams YouTube
https://i.ytimg.com/vi/uG7EBeQaJTU/maxresdefault.jpg
Therefore 1st is correct and 1th is incorrect Definition of 1st 1st the ordinal number indicating the first position of objects just at the beginning The children sat in the first row I still Ordinal numbers are numbers that show position or order in a sequence For example the words first and twentieth are ordinal numbers as are numerals with suffixes at
[desc-10] [desc-11]
Winding Spiral Case Medical School Schedules Exams
https://4.bp.blogspot.com/-fIhPOxMJAVo/VPIXBfEEddI/AAAAAAAAFkg/7tq_JrZ-TaE/s1600/ubc%2Bmedicine%2Bschedule.jpg
Dear Medical Student Letter To A Third Year Medical School Clerkship
https://blog.amboss.com/hubfs/Blog_1200x628-v03.jpg-2.jpg

https://writingtips.org
1st is the correct numeric abbreviation of first 1th is a grammatical error and you should never use it Remembering how to correctly write ordinals can be challenging

https://www.englishclub.com › vocabulary › numbers-ordinal.php
This page shows how we make and say the ordinal numbers like 1st 2nd 3rd in English Vocabulary for ESL learners and teachers

What A First Year Medical School Student Can Expect

Winding Spiral Case Medical School Schedules Exams

Medical Students 2011 A Cervantes INTRODUCTION TO CANCER TREATMENT

Training Plan Template Templates At Allbusinesstemplates

Medical School Admissions Requirements 2020 2021

Cardiac Tamponade PPT

Cardiac Tamponade PPT

2 VS ppt
Staphylococcus Streptococcus Bacteriological Diagnosis ii PPT

Rotary Club Of Colleyville Me Squared Cancer Foundation
1st Year Medical School Classes - When writing ordinal numbers such as 1st 2nd 3rd etc you should use the last two letters on the word as it would be if you wrote out the whole word Below are the ordinal numbers both